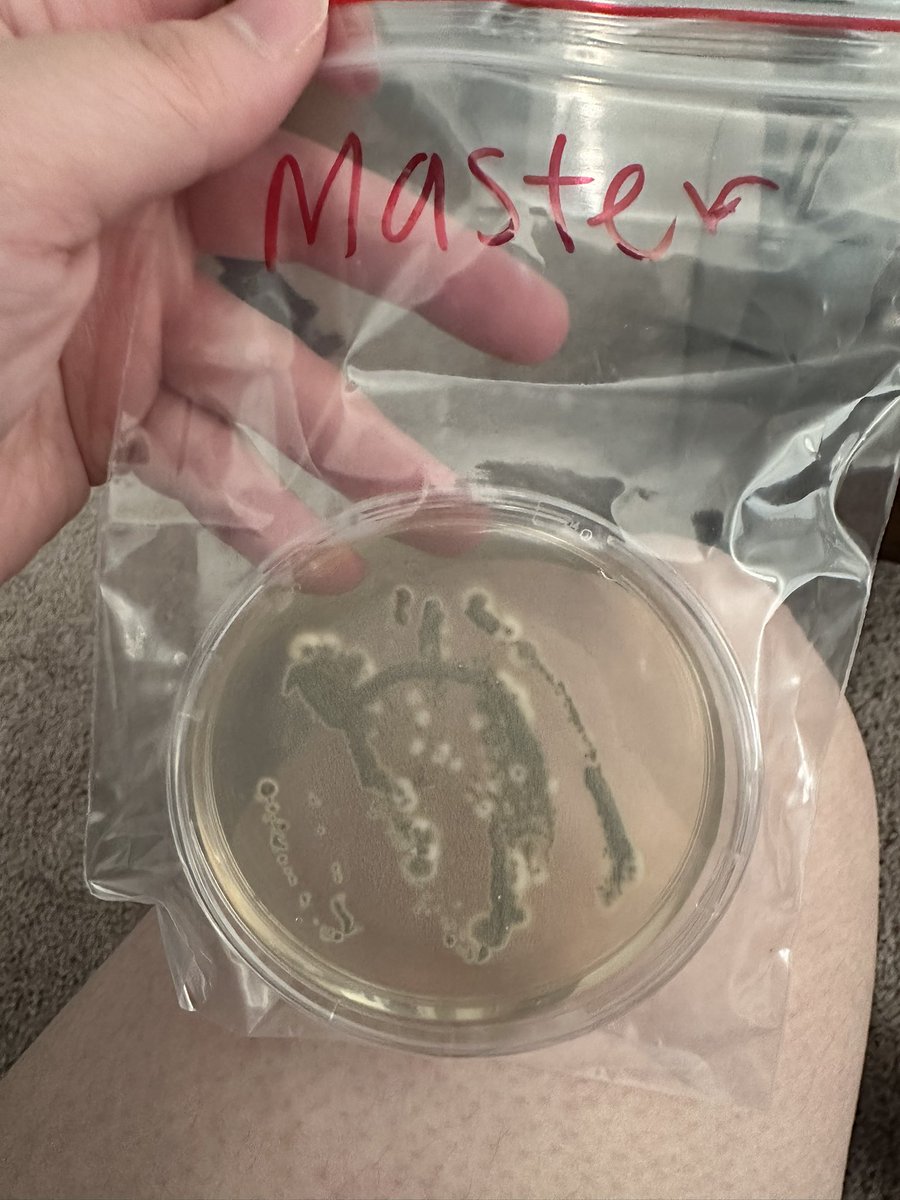
FrtingGlitter tweet media

finny
746 posts


finny
@punzosbee
🌟 — if i like you, i’m babbling your ear off
22 ૮ . . ྀིა she they Katılım Ağustos 2022
28 Takip Edilen14 Takipçiler
finny retweetledi

@wenisprinkles miss u teensa, i think about you a lot ahhhh i hope you’re okay. so much happened, i wasnt able to catch streams :( 💗
English

Just living my life ahahaHAHAHAHAHAHAHAHA

FrtingGlitter@wenisprinkles
With everything going on right now, we found mold in our apartment vents. 🫠 I’m so worried for my cats the longer we stay there. 🥲
Filipino

For whoever cares,
2 years ago, Blu (my VERY shy kitty) she would run away when you’d walk towards her, she didn’t talk to you much, hesitant to be picked up and loved on.
NOW! Blu is so playful, always looking for love and affection, she chirps at you when you talk to her and holds conversations with you, she’s becoming comfy with being on her back, and she’s now a lap cat. 🥹


English

Seeing Flexinja talk about mental health makes me want to talk about mine too.
I’m a big advocate for speaking up about mental health and I sometimes share what I’m struggling with too but I haven’t been fully transparent about it lately. Mostly out of shame and I didn’t want to worry/scare anyone.
Past month and a half or so I’ve been having suicidal thoughts and depression and lots of anxiety.
**I want to immediately clarify that while I do have these thoughts, I will never act on them.**
It’s been hindering my motivation to stream and finish up my subathon and working my other job as well. It’s not new that I have anxiety but whenever I’d have these dark feelings, my anxiety amplifies and I can’t shake it. In that moment I feel stuck with those really dark thoughts.
Fortunately, I do have a great support system. I am going to therapy, I have my wonderful patient boyfriend and his family that I absolutely adore and they adore me. I guess I just wanted to talk about it and let others know that these feelings and thoughts do happen and that it’s important to recognize them and act accordingly.
Reach out to people, surround yourself with love, and TALK ABOUT IT!
I can’t stress that enough.
You matter. Your life matters.
English







